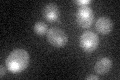
YNL072W
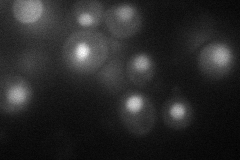
YNL072W
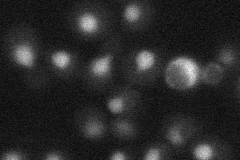
YNL072W
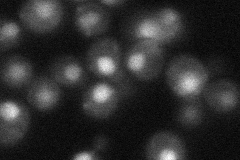
YNL072W
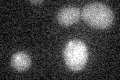
YNL072W

View description
Ribonuclease H2 catalytic subunit, removes RNA primers during Okazaki fragment synthesis; homolog of RNAse HI (the S. cerevisiae homolog of mammalian RNAse HII is RNH1); related to human AGS4 that causes Aicardi-Goutieres syndrome
Localization:
Intensity:
Fold change:
Significance:
-
C’ GFP library in SD
nucleus20.66 -
N' NOP1pr-GFP in SD
nucleus50.6921 -
N' TEF2pr-mCherry in SD
nucleus12.6034 -
N' NATIVEpr-GFP in SD
nucleus32.946 -
N' TEF2pr-VC and Cyto-VN in SD

#N/A0 -
C’ GFP library in SD+DTT

nucleus20.350.98No -
C’ GFP library in SD+H2O2

nucleus20.891.01No -
C’ GFP library in Starvation Media
nucleus14.790.71Yes -
C’ GFP library on the background of Pup2-DaMP

nucleus -
C’ GFP library on the background of CCT mutant

nucleus20.38680.986645No
